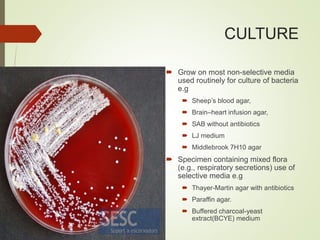
CULTURE
 Grow on most non-selective media
used routinely for culture of bacteria
e.g
 Sheep’s blood agar,
 Brain–heart infusion agar,
 SAB without antibiotics
 LJ medium
 Middlebrook 7H10 agar
 Specimen containing mixed flora
(e.g., respiratory secretions) use of
selective media e.g
 Thayer-Martin agar with antibiotics
 Paraffin agar.
 Buffered charcoal-yeast
extract(BCYE) medium
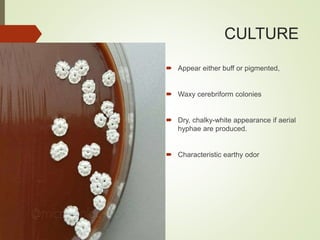
CULTURE
 Appear either buff or pigmented,
 Waxy cerebriform colonies
 Dry, chalky-white appearance if aerial
hyphae are produced.
 Characteristic earthy odor
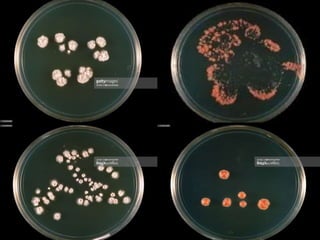

This document discusses the aerobic actinomycete Nocardia. It begins by classifying Nocardia taxonomically and noting it is an opportunistic pathogen found in soil. The document then covers the epidemiology, pathogenesis, clinical manifestations including pulmonary, skin and disseminated infections, diagnosis through microscopy, culture and molecular methods, and treatment with antimicrobials. In summary, Nocardia is an environmental actinomycete that can cause infection in immunocompromised individuals, with pulmonary disease being most common and diagnosis relying on microscopy, culture and molecular identification methods.